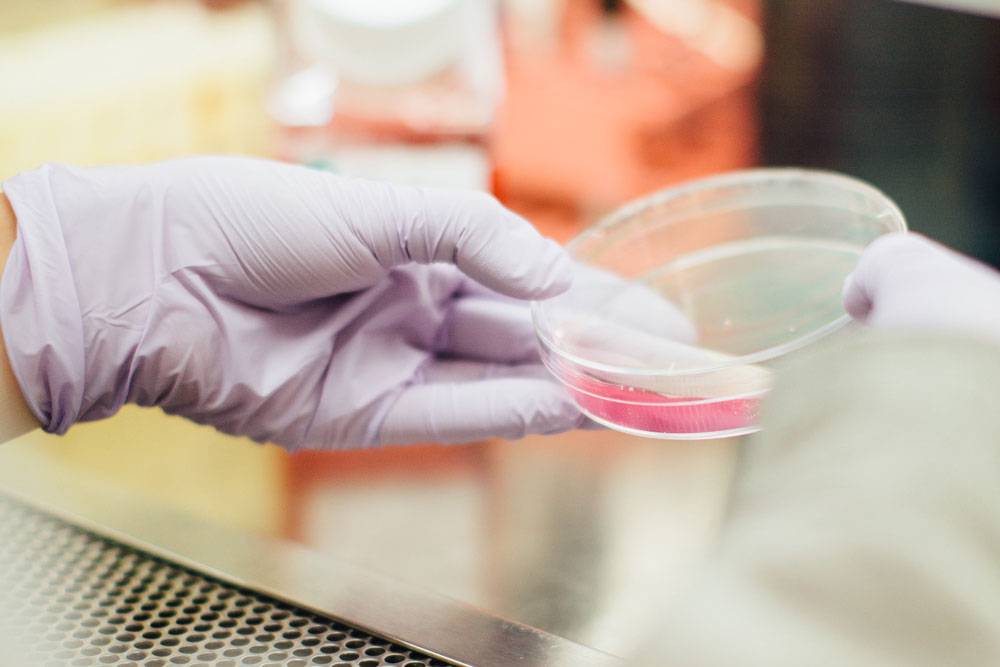

(Contractpharma) AbbVie and Gedeon Richter Enter Co-Development and License Agreement
AbbVie and Gedeon Richter Plc. have entered a new co-development and license agreement to research,
...